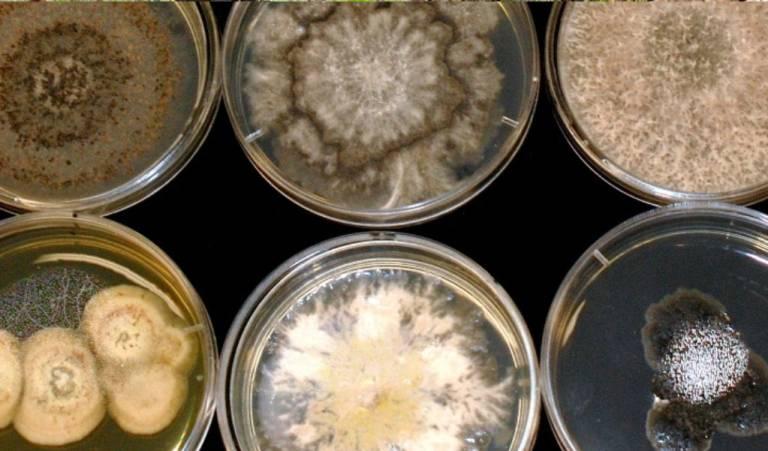

Todas las Partes del Hongo; también las partes del micelio y las esporas

Descubre el mundo oculto y maravilloso de los hongos, donde cada parte juega un papel vital en un ciclo de vida complejo y hermoso. El Micelio, la red subterránea que alimenta y sostiene, es el corazón latente del hongo, descomponiendo y absorbiendo nutrientes del sustrato. El Cuerpo Fructífero, la parte visible y a menudo espectacular, es una obra maestra de la naturaleza diseñada para la reproducción, con formas y colores que despiertan la imaginación. Las Esporas, semillas microscópicas de vida, llevan la promesa de nuevos comienzos, listas para viajar y colonizar nuevos territorios. Desde la biología hasta la gastronomía y la medicina, los hongos tienen un impacto profundo en nuestras vidas y nuestro mundo. Únete a nosotros en un viaje de exploración y asombro, y aprende cómo estas tres partes esenciales del hongo trabajan juntas en una sinfonía de vida y crecimiento. ¡La naturaleza nunca ha sido tan intrigante!